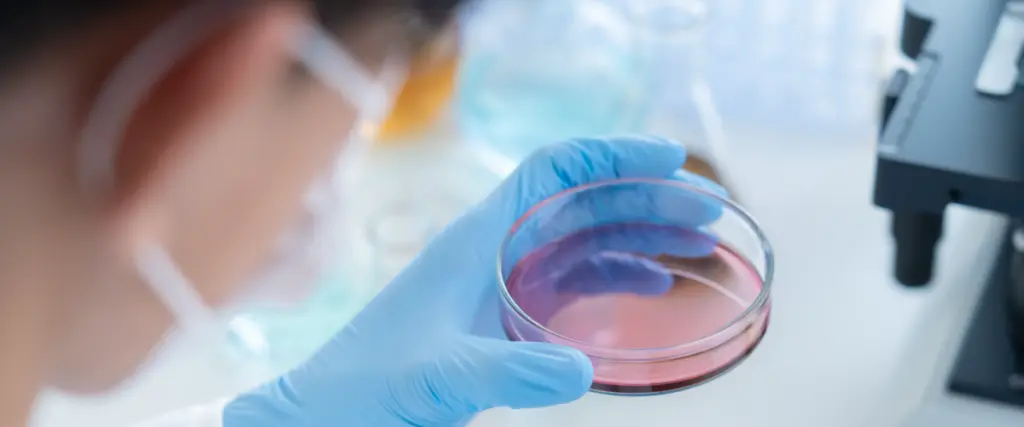

新たな挑戦に共に取り組み、
成長していける仲間を募集しています。
2026年度にグラングリーン大阪ゲートタワー5階で、保険診療と自由診療を融合した次世代型クリニックを開設予定です。保険診療では、内科・小児科を中心に「子育て世代を応援する医療」をテーマに掲げ、家族全員が安心して通院できる診療体制を整えます。一方、自由診療では、最先端の美容医療や再生医療を提供し、患者さん一人ひとりの「美」と「健康」の実現をサポートします。
これらを通じて、医療の力で地域社会に笑顔と安心を届けることを目指します。私たちのクリニックは、子どもたちの健やかな成長を支え、ご家族の生活をより豊かにするための「未来を創る医療」を提供します。ぜひ、私たちと一緒に新しい医療の形を創り上げていきましょう。